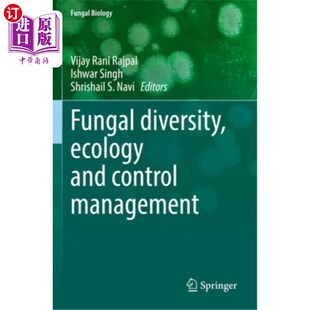
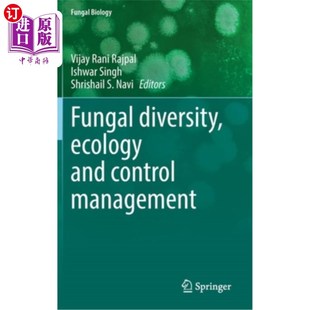

Detection and Plant 植物病原微生物检测与疾病诊 Fungal Pathogens Diagnosis 海外直订Microbial Disease
¥2067满999减100售0件

Detection and Plant 微生物植物病原体检测和疾病 Fungal Pathogens Diagnosis 海外直订Microbial Disease
¥2067满999减100售0件

Problems Infections and Remedy 问题和治疗 海外直订医药图书Combating 对抗真菌感染 Fungal
¥2067满999减100售0件

发生 Spore 植物和动物真菌孢子与疾病 Animals Plants Initiation Disease and Fungal 海外直订The
¥2067满999减100售0件

真菌与植物 Interactions 相互作用 Plant 海外直订Fungal
¥2067满999减100售0件

Problems Infections and Remedy 问题和治疗 海外直订医药图书Combating 对抗真菌感染 Fungal
¥2067满999减100售0件

Art and Wild Fungal Nature真菌灵感艺术插图灵感来自自然平面设计书籍 Inspiration Inspired 英文原版 Illustration
¥208满99减10售0件

Groups 海外直订Trichomycetes Fungal Other 毛菌和其他真菌类群 and
¥2081满999减100售0件

and 传染病临床微生物学 Clinical Diseases Viral Infectious the Microbiology Par 海外直订医药图书Atlas Fungal
¥2081满999减100售0件

Bioremediation Fungal 预售 按需印刷
¥2188满800减104售0件

预订Fungal Pathology
¥2138满800减100售0件

Fungal Biology Current 真菌生物学实验室协议:真菌生物学 海外直订Laboratory Methods Protocols
¥2208满999减100售0件

and the Bacterial Fungal System Gastrointestinal 胃肠系统外科病理 海外直订医药图书Surgical Viral Pathology
¥2220满999减100售0件

Fungal 9781402000508 Diseases Rice 预订Major
¥2222满800减100售0件

Soilborne Fungal Diseases Atlas 土传真菌植物病原体和病害图集 and Pathogens 海外直订Pictorial Plant
¥2235满999减100售0件

and Resources Current 海外直订Fungal Future 真菌资源 Sustainable 可持续经济中 for 现 Economy Perspectives Status
¥2274满999减100售0件

Products 人类福利和生物技术中 and 真菌和真菌产品 Biotechnology Fungal Welfare 海外直订Fungi Human
¥2274满999减100售0件

Organization Fungal Its 真菌群落 海外直订The Edition and Community Ecosystem the Role 它在生态系统中 Fourth
¥2299满999减100售0件
and Ecology Control Management 生态学与控制管理 海外直订Fungal 真菌多样性 Diversity
¥2299满999减100售0件
and Ecology Control Management 生态学与控制管理 海外直订Fungal 真菌多样性 Diversity
¥2299满999减100售0件

Metabolites Fungal 预订
¥7118满1999减300售0件

海外直订Fungal 真菌病理学 Pathology
¥2493满999减100售0件

Plants and Crops 真菌发病机制 海外直订Fungal 植物和作物中 Pathogenesis
¥2653满999减100售0件

9780471166153 预订Fungal Physiology
¥2653满800减100售0件

海外直订The true stories Tree dozen 在这个注意 怪异 真菌族谱 Family semi era this shrinkin Fungal Freaky
¥135满99减5售0件

海外直订医药图书Fungal 真菌基因组学 Genomics
¥2773满999减100售0件

And Stain Other Dreams 按需印刷The 9780977173433 Fungal
¥285满200减10售0件

Fungal Biology Current 真菌生物学实验室协议:真菌生物学 海外直订Laboratory Methods Protocols
¥2886满999减100售0件

人类真菌病原体 Pathogens 海外直订医药图书Human Fungal
¥2894满999减100售0件

人类真菌病原体 Pathogens 海外直订医药图书Human Fungal
¥2894满999减100售0件